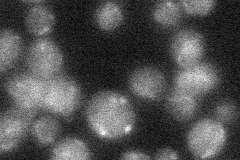
YOL101C
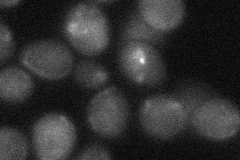
YOL101C
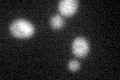
YOL101C

View description
Membrane protein involved in zinc ion homeostasis, member of the four-protein IZH family, expression induced by fatty acids and altered zinc levels; deletion reduces sensitivity to excess zinc; possible role in sterol metabolism
Localization:
Intensity:
Fold change:
Significance:
-
C’ GFP library in SD

below threshold14.64 -
N' NOP1pr-GFP in SD

punctate,vacuole49.0404 -
N' TEF2pr-mCherry in SD

cell periphery,vacuole85.2821 -
N' NATIVEpr-GFP in SD
below threshold19.1031 -
N' TEF2pr-VC and Cyto-VN in SD
below threshold24.3145 -
C’ GFP library in SD+DTT
cytosol14.791.01No -
C’ GFP library in SD+H2O2

cytosol15.361.04No -
C’ GFP library in Starvation Media

cytosol15.681.07No -
C’ GFP library on the background of Pup2-DaMP

below threshold -
C’ GFP library on the background of CCT mutant

below threshold15.51521.0597No
